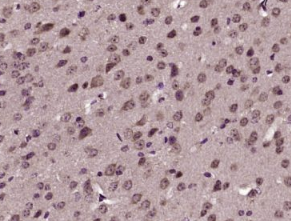

英文名称:B-Raf
中文名称:B Raf抗体
抗体来源:兔子
克隆类型:多克隆
交叉反应:人、小鼠、大鼠、鸡、狗、猪、牛、马、兔、斑马鱼、绵羊
产品应用:IHC-P=1:100-500 IHC-F=1:100-500 ICC=1:100-500 IF=1:100-500(石蜡切片需做抗原修复)
分 子 量:84kDa
细胞定位:细胞核 细胞浆 细胞膜
状态:冻干或液体
浓度:1mg/ml
来源于:KLH conjugated synthetic peptide derived from human B-Raf :301-400/766
亚型:IgG
纯化方法:affinity purified by Protein A
储存液:0.01M TBS(pH7.4) with 1% BSA, 0.03% Proclin300 and 50% Glycerol.
别 名:94 kDa B raf protein; B raf 1; B Raf proto oncogene serine threonine protein kinase; BRAF 1; Braf; BRAF1; cRmil; MGC126806; MGC138284; Murine sarcoma viral (v-raf) oncogene homolog B1; Murine sarcoma viral v raf oncogene homolog B1; p94; RAFB 1; RAFB1; v raf murine sarcoma viral oncogene homolog B1; FLJ95109; BRAF_HUMAN.
保存条件:在-20°C下保存一年。避免反复冻融。冻干抗体在室温下至少稳定一个月,并在-20°C下保持一年以上。当在无菌pH7.4 0.01M PBS或抗体稀释剂中重组时,抗体在2-4°C下至少稳定两周。
产品介绍:
raf激酶是信号转导的重要中间产物。raf蛋白家族成员,包括a raf和b raf,具有内在丝氨酸/苏氨酸激酶活性。ras蛋白和raf蛋白的相互作用导致raf介导的磷酸化和mek(也称为map激酶激酶)的激活。BRAF的缺陷涉及多种癌症。b-raf是一种丝氨酸/苏氨酸蛋白激酶,作为从膜相关受体到核转录因子的信号转导物。1 BRAF对胚胎发生过程中细胞增殖的调控和细胞命运的确定具有重要意义。BRAF在ras-raf-mek-erk信号转导途径中作用于ras的下游和mek的上游,这是一种保守的ras活化蛋白激酶级联,调节细胞生长、增殖和分化,以响应生长因子、细胞因子和激素。
子单元:
单体。同二聚体。与raf1异二聚体,并且异二聚体具有比各自的同二聚体或单体高的激酶活性。异二聚化是由14-3-3蛋白调节和增强的有丝分裂原。MAPK1/ERK2激活可通过磷酸化THR-753处的BRAF来诱导负反馈,从而促进异二聚体的离解。发现于至少含有braf、hras1、map2k1、mapk3和rgs14的复合体中。与RIT1互动。(通过N端)与RGS14(通过RBD域)相互作用;该相互作用介导与raf1形成三元复合物,raf1是一种被gnai1抑制的三元复合物。与Dgkh互动。
亚细胞位置:
原子核。细胞质。细胞膜。
组织特异性:
大脑和睾丸。
相似性:
属于蛋白激酶超家族。tkl-ser/thr蛋白激酶家族。
含有1个佛波酯/DAG型锌指。
包含1个蛋白激酶域。
包含1个RBD(RAS绑定)域。
重要提示:
本产品仅用于研究用途,不用于人类、治疗或诊断应用
BRAF蛋白是有丝分裂原活化的蛋白激酶/细胞外信号调节激酶途径蛋白。正常的B-Raf蛋白的功能是传递来自细胞膜的信号,在Ras-Raf-MEK-ERK信号转导调节途径中有着重要的作用.
BRAF是在癌细胞的生长和存活中起到关键作用的蛋白质,并且在大多数恶性黑素瘤患者和少数结肠癌、乳腺癌和肺癌患者中发生突变,目前BRAF也用于恶性黑素瘤和肿瘤的研究。
多聚甲醛固定,石蜡包埋(小鼠脑);用柠檬酸钠缓冲液煮沸(15分钟)提取抗原;用3%过氧化氢阻断内源性过氧化物20分钟;阻断缓冲液(正常山羊血清)37℃30分钟;抗体孵育(Ⅱ)多克隆A在4°C下1:400整晚未结合的全身,然后根据SP试剂盒(兔子)说明和DAB染色进行操作。
公司优势:
1)质量:我司提供的的试剂为世界。
2)价格:价格实惠,量大从优。
4)服务:提供完整的售前、售后和售中服务。售后到底。
如需订购B-Raf,请联系我们。
| Anti-M2-PK (pyruvate Kinase M2) 丙酮酸激酶-M2(小鼠来源抗体) |
| Anti-Integrin αM/CD11b (Mac-1/CR3A)(Integrin-alpha2) 巨噬细胞表面分子/整合素-α2抗体 |
| Anti-ChRM1 (muscarinic acetylcholine receptor) 毒蕈碱型乙酰胆碱受体M1抗体 |
| Anti-MADCAM-1(-Mucosal addressin cellular adhesion molecule-1) 粘膜选址素抗体 |
| Anti-MAG-a/b (Myelin associated glycoprotein; L / S -MAG;) 髓鞘相关糖蛋白a/b抗体 |